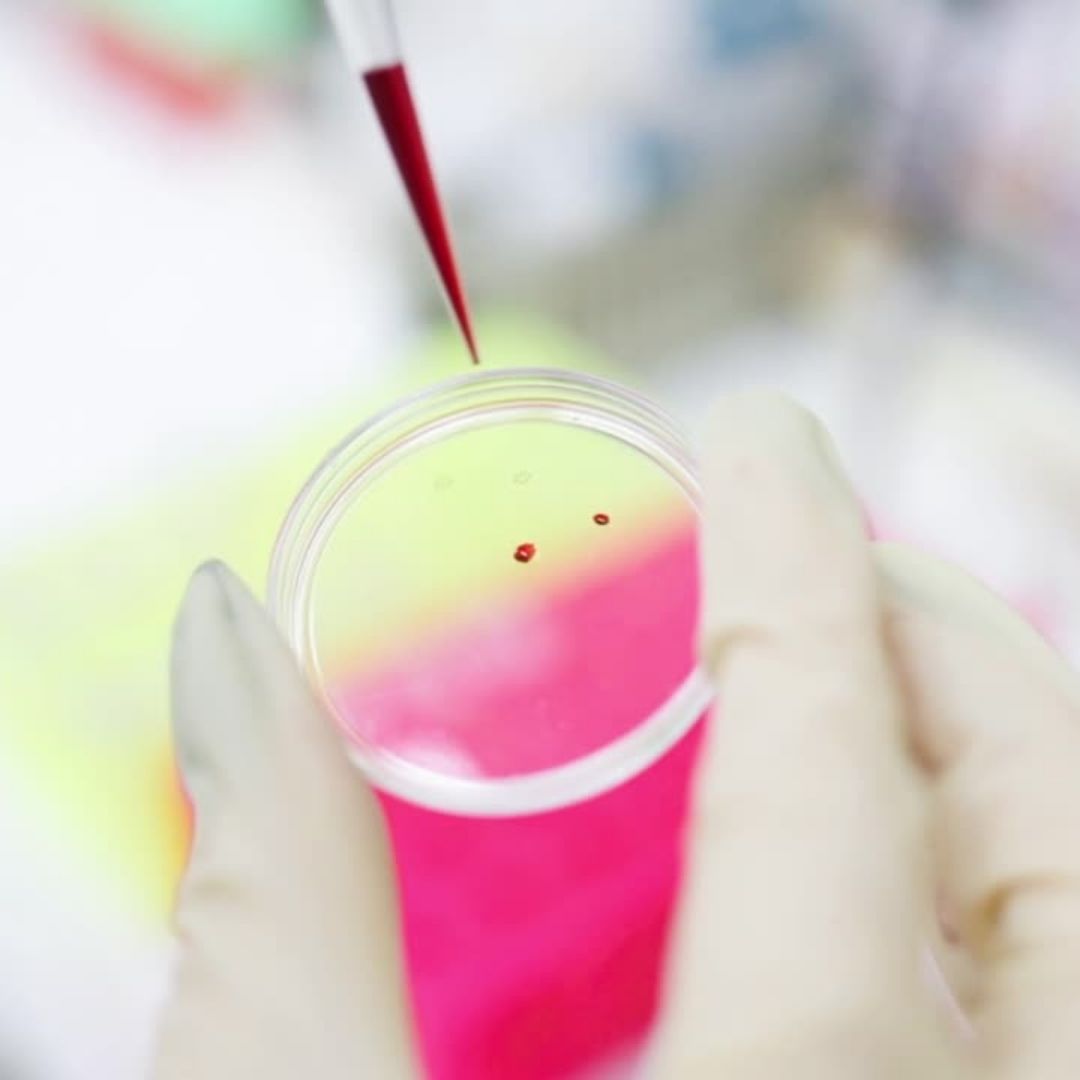

유전자와 바이오 산업
최근에는 가정에서 유전자를 통해서 자신의 DNA에 포함된 유전형질을 알아내는 검사 키트도 판매되는 등 유전자를 활용한 제품들과 이를 활용한 의약품들 개발이 활발히 이루어지고 있습니다.
유전자는 세포 염색체를 형성하는 DNA를 구성하는 유전적 단위를 말합니다. 최근 우리의 유전자 분석을 통해서 유전자 기능과 성질, 염색체 상의 위치 등을 알아내어 치료에 활용하려는 시도가 이루어지고 있습니다. 그러면서 동시에 이와 관련된 산업에 대한 관심도 함께 높아지고 있는 중입니다.



유전체검 관련주 동향
진원생명과학 주가가 20일 전날 대비 11.82%가 오른 5만 7700원, 우정바이오가 전일 대비 4.38%오른 8110원을 기록하며 더욱 관심을 모으고 있습니다. 이외에도 씨젠, 엑세스바이오, 천랩, 랩지노믹스 등이 상승하는 모습을 보였습니다.



그렇다면 유전자 관련 사업을 하는 회사들엔 어떤 것들이 있을까요? 다음에서 알아보겠습니다.
유전자 관련주, 유전자 관련 사업을 하는 회사
유전자 관련 사업을 하는 바이오 회사에는 씨젠, 엑세스바이오, 소마젠, 제노포커스 등이 있습니다. 다음에서 어떤 사업을 하는지 간략히 소개 해 드리겠습니다.
엑세스바이오는 유전자 결핍 진단키트인 G6PD RDT를 생산하는 회사이고, 자회사인 웰스바이오는 다중 유전자 동시 증폭 분자진단 기술을 확보하고 있어 유전자와 관련된 기술을 보유하고 있습니다.
또 씨젠은 유전자 단위인 DNA, RNA 분석을 통해 질병의 원인을 감별하는 분자진단을 핵심사업으로 영위하고 있어 유전자 치료 및 유전자 사업 관련 회사에서 빼놓을 수 없는 회사입니다.

소마젠은 작년에 상장한 회사로 유전체 분석 서비스인 NGS, CES를 주요 제품으로 하고 있습니다. 현재 미국 전역에서 대학 및 관련 기관에 유전체 분석 솔루션 서비스를 제공하고 있어 그 기술과 능력에서 인정받고 있습니다.
제노포커스는 산업용 효소와 기초 의약물질 및 생물학적 제제 제조를 하는 회사로 현재 마이크로바이옴 신약개발 진행 중에 있습니다. 신규 유전자원 발굴 및 유전체 기술도 보유하고 있어 기대가 되는 부분입니다.

EDGC는 글로벌 헬스케어 전문 기업으로 최첨단 유전자 분석 기술과 바이오인포매틱스 기술을 기반으로 유전자를 분석해 질병 예방을 위한 개인 맞춤형 치료 플랜을 제공하고 있습니다. 그 외에도 비침습 산전검사와 신생아 유전체검사, 융합형 건강검진, 암과 일반질환 예측검사와 같은 제품도 제공하고 있으며 최근에 캐나다 건강기능식품 회사를 인수하여 호재가 계속 이어지고 있는 중입니다.
그리고 오늘 많은 상승폭을 보였던 진원생명과학은 임상시험에 필요한 유전자치료제와 DNA 백신의 원료인 국제규격 플라스미드 DNA 제품을 미국 현지법인인 VGXI, Inc.에서 생산 판매하고 있는 회사로 유전체치료 관련주 중에서도 눈여겨 보아야 할 회사입니다.
앞으로 계속 눈여겨 봐야 할 기술, 유전체치료
유전자 치료, 유전체치료 기술은 앞으로도 계속해서 눈여겨 봐야 할 분야입니다. 이제 시작인 분야이고, 이제 개인에게도 점점 침투하고 있는 분야이기 때문에 위의 회사들을 주목 해 두고 주가를 확인 해 보는 것이 좋을 것 같습니다.
다른 주식관련 정보가 궁금하시다면 다른 글들을 확인 해 주세요.
이 자료는 참고용이며, 증권투자는 반드시 본인의 판단하에 하여야 하며, 투자의 책임은 투자자 본인에게 있습니다.
'경제생활' 카테고리의 다른 글
| 코로나 백신 접종 후 주의사항 (0) | 2021.07.23 |
|---|---|
| SK 중간배당 금액 얼마? 중간배당 주는 국내주식 찾기 (0) | 2021.07.22 |
| 소상공인 재난지원금 희망회복자금 지급 시기 (0) | 2021.07.17 |
| 숨어있는 노후자금 찾는 방법: 숨은 내 돈 찾기 (0) | 2021.07.17 |
| 에스디바이오센서와 씨젠 등 진단키트 관련주 (0) | 2021.07.16 |
댓글